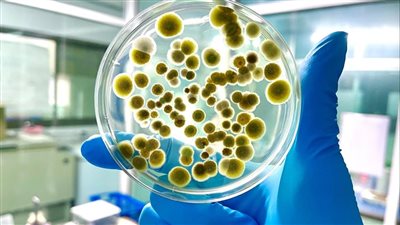

مؤشر سوق الأسهم السعودية يغلق مرتفع

أغلق مؤشر الأسهم السعودية الرئيس خلال تعاملات جلسة، اليوم الأثنين، مرتفعاً بمقدار 13.36 نقطة، ليصل إلى مستوى 10488.91 نقطة، وبتداولات بلغت قيمتها 7.2 مليار ريال.

وبلغت كمية الأسهم المتداولة 277 مليون سهم، سجلت فيها أسهم 74 شركة ارتفاعاً في قيمتها، فيما تراجعت أسهم 189 شركة.
وكانت أسهم شركات "ثمار"، و"تكافل الراجحي"، و"البحري"، و"الصناعات الكهربائية"، و"العربية" الأكثر ارتفاعاً، أما أسهم شركات "سهل"، و"طيران ناس"، و"سينومي سنترز"، و"مجموعة إم بي سي"، و"رتال" الأكثر انخفاضاً في التعاملات، وتراوحت نسب الارتفاع والانخفاض ما بين 5.60% و6.41%.
فيما كانت أسهم شركات "أميركانا"، و"أرامكو السعودية"، و"الراجحي"، و"الصناعات الكهربائية"، و"الأهلي" هي الأكثر نشاطاً بالكمية، بينما كانت أسهم شركات "الراجحي"، و"أرامكو السعودية"، و"الأهلي"، و"الإنماء"، و"علم" هي الأكثر نشاطاً في القيمة.
وأغلق مؤشر الأسهم السعودية الموازية "نمو" اليوم منخفضاً بمقدار 65.12 نقطة، ليصل إلى مستوى 22532.90 نقطة، وبتداولات بلغت قيمتها 13 مليون ريال، وبلغت كمية الأسهم المتداولة أكثر من 2.2 مليون سهم.
الأسهم الأوروبية تلامس أدنى مستوى في أسبوعين متأثرة بصراع الشرق الأوسط

انخفضت أسواق الأسهم الأوروبية خلال تعاملات جلسة، اليوم الاثنين، مع عدم ظهور أي بوادر على التهدئة في الصراع العسكري بالشرق الأوسط، في حين قفزت أسهم قطاعي الطاقة والدفاع.
وتراجع مؤشر ستوكس 600 الأوروبي في أسواق الأسهم الأوروبية بنسبة 1.8% ليسجل أدنى مستوى منذ منتصف فبراير عند 622.35 نقطة، وتراجع من أعلى مستوى قياسي سجله يوم الجمعة، مع تداول معظم القطاعات على انخفاض.
وقفزت أسهم شركات الطاقة الكبرى "شل" و"بي بي" و"توتال إنرجيز" في أسواق الأسهم الأوروبية بأكثر من 5% لكل منها، مستفيدة من صعود النفط بنحو 13% بعد تعطل الشحن في مضيق هرمز الحيوي بسبب الرد الإيراني على الهجمات الأميركية والإسرائيلية، وصعد مؤشر الطاقة 3.5% .
واستمرت الضربات العسكرية الجديدة التي شنتها الولايات المتحدة وإسرائيل على إيران بعد الهجمات التي وقعت في عطلة نهاية الأسبوع وأدت إلى مقتل الزعيم الأعلى الإيراني آية الله علي خامنئي، مما دفع طهران إلى إطلاق وابل من الصواريخ في أنحاء المنطقة وأثار مخاوف من اتساع رقعة الصراع واحتمال انخراط الدول المجاورة فيه.
وسجلت أسهم قطاع السفر والترفيه، التي تشمل شركات الطيران والفنادق، أكبر انخفاض، إذ تراجعت 4.4%، مع انخفاض سهم "لوفتهانزا" 11% بعد أن مددت شركة الطيران الألمانية تعليق رحلاتها بسبب الوضع في الشرق الأوسط، وتراجع مؤشر البنوك 3.6%، بينما خسر مؤشر شركات التأمين نحو 2%.
وعلى الجانب الآخر، ارتفعت أسهم شركات الدفاع مثل "بي إيه إي سيستمز" و"راينميتال" و"ساب" و"ليوناردو" بنسب تتراوح بين 5% و8%، وزاد مؤشر شركات الدفاع 0.4% مع تصاعد الصراع الذي عزز التوقعات بزيادة الإنفاق الدفاعي الأمريكي.




 تابعوا آخر أخبار بوابة الوفد الإلكترونية عبر نبض
تابعوا آخر أخبار بوابة الوفد الإلكترونية عبر نبض